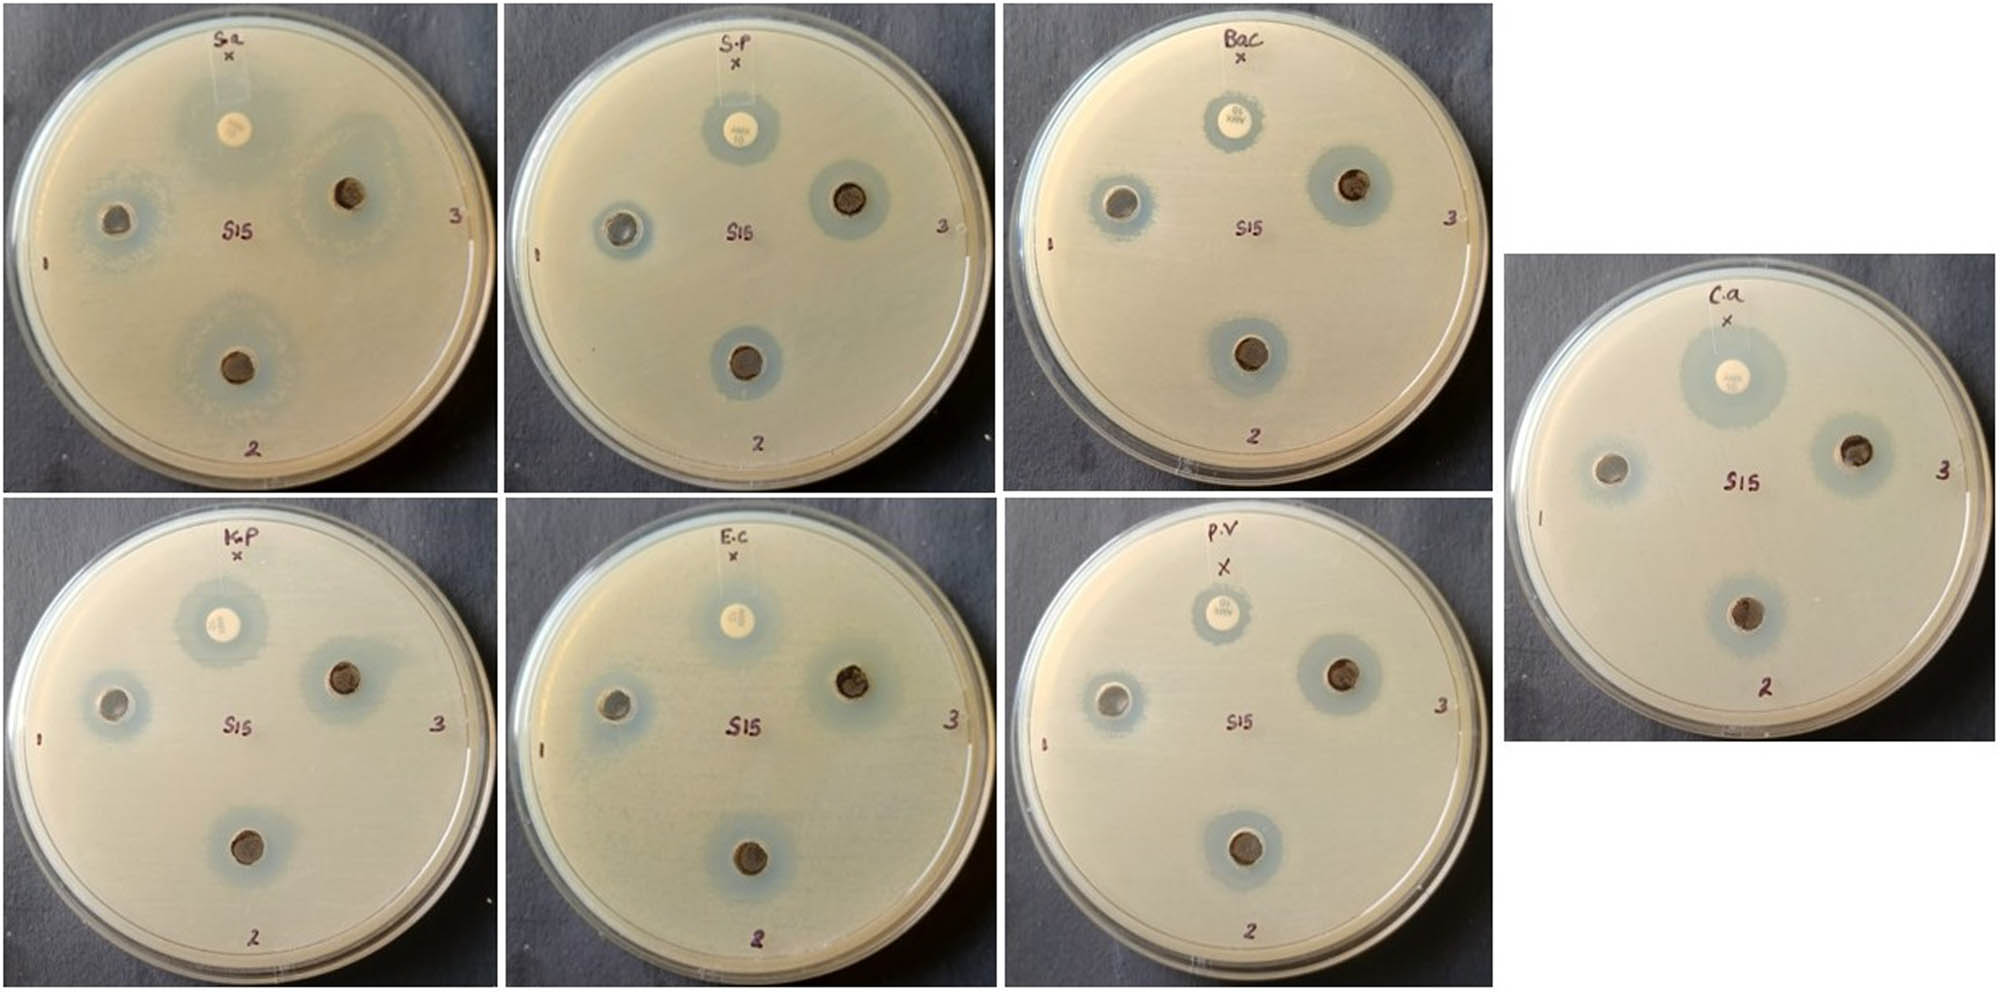
Figure 6 
                  Antimicrobial activity of the synthesized GO/Mn/Ch/FA-Brucine NCs. The treatment of various concentrations of the synthesized GO/Mn/Ch/FA-Brucine NCs effectively decreased the growth of tested pathogens, particularly E. coli, S. aureus, and C. albicans, which were more sensitive to the NCs.

Graphene oxide/chitosan/manganese/folic acid-brucine functionalized nanocomposites show anticancer activity against liver cancer cells
-
Abdullah R. Alzahrani
, Ibrahim Abdel Aziz Ibrahim, Ibrahim M. Alanazi
, Naiyer Shahzad , Imran Shahid , Mohd Fahami Nur Azlina , Yusof Kamisah , Nafeeza Mohd Ismail and Palanisamy Arulselvan
Abstract
Nanomedicine is the application of nanomaterials and nanotechnology to the development of novel pharmaceuticals and drug delivery mechanisms. The present study synthesized a functionalized nanocomposite (NC) containing graphene oxide (GO), chitosan (Ch), manganese (Mn), folic acid (FA), and brucine. The anticancer properties of the synthesized GO/Mn/Ch/FA-Brucine NCs were evaluated against liver cancer cells. GO/Mn/Ch/FA-Brucine NCs were characterized using several characterization techniques. The growth of HepG2 and Hep3B cells was analyzed using the methylthiazolyldiphenyl-tetrazolium bromide assay. The cell apoptosis was examined through dual staining. The levels of inflammatory and oxidative stress biomarkers were measured using the corresponding assay kits. Various characterization assays revealed the formation of crystalline GO/Mn/Ch/FA-Brucine NCs with tetragonal and agglomerated morphologies, various stretching and bonding, and an average particle size of 136.20 nm. GO/Mn/Ch/FA-Brucine NCs have effectively inhibited the viabilities of HepG2 and Hep3B cells. The NCs increased thiobarbituric acid reactive substances and reduced antioxidants and inflammatory mediators, thereby promoting apoptotic cell death in HepG2 cells. Our findings indicate that GO/Mn/Ch/FA-Brucine NCs can inhibit viability and promote apoptosis in liver cancer HepG2 cells.
1 Introduction
Liver cancer is the third major cause of mortality worldwide, despite extensive research efforts devoted to its treatment. The prevalence of this disease is higher among males than females [1,2]. A report submitted to the World Health Organization by the International Agency for Research on Cancer has included the findings on the global incidence of liver cancer in the year 2020, indicating that a total of 905,700 individuals were diagnosed with this disease, and out of this diagnosed population, 830,200 individuals died due to liver cancer. According to the reports, it was projected that the incidence and mortality rates of liver cancer may increase by 55% by the year 2040 [3,4]. The major problem with treating liver cancer is that it is usually identified at a late stage. Therapeutic procedures, such as resection or transplantation, can be applied only to a small percentage of patients [5]. In order to address the limitations of current techniques, there is an ongoing pursuit to identify new anticancer drugs that exhibit enhanced efficacy while minimizing adverse effects. Several targeted therapeutics have been identified for the management of liver cancer; nevertheless, their effectiveness against cancer cells has been limited [6].
Nanocomposite (NC) materials consist of many phases, each exhibiting dimensions at the nanoscale ranging from one to three nanometers. The understanding of the relationship between structure and property is significantly impacted by the proportion of surface area to volume of the material employed in the formulation of NCs [7]. NCs offer a plethora of innovative solutions for tackling challenges across diverse sectors such as medicine, foods and beverages, and electronics. The physical attributes of the nanocrystals possess potential usage in the advancement of new and potential sensors for tumor detection, tumor imaging, and pharmaceuticals for cancer treatment [8].
Ch, a naturally occurring polysaccharide, is commonly present in certain seafood types, including shrimp, crab, and crayfish, with the highest concentration found in their shells. Ch possesses several key characteristics, namely biocompatibility, biodegradability, and non-toxicity [9,10]. Graphene oxide (GO) exhibits hydrophilic properties and high dispensability in aqueous and organic solvents because of the occurrence of oxygen-containing functional groups [11]. Due to its distinctive properties, GO exhibits significant promise in the fields of nanomedicine and biomedical applications [12]. GO has been the subject of study in the area of drug delivery due to its significant hydrophobic surface area, which facilitates the loading of hydrophobic medicines through non-covalent adsorption [13]. The large surface area of GO and the existence of oxygenated functional groups facilitate the implementation of several techniques for modifying nanomaterials. These techniques include chemical functionalization and the application of molecules and polymers as coatings. These modifications are employed to design drug delivery systems [14].
In the context of functionalization, GO exhibits a notable benefit compared to other nanocarriers. This advantage primarily relies on the abundant occurrence of carboxylic groups, which facilitates the coupling of several molecules compared to other nanocarriers like liposomes and solid lipid nanoparticles. Furthermore, it has been observed that an increased level of functionalization of GO can enhance the functionality of the nanocarrier [15]. Brucine is a major bioactive compound derived from the Strychnos nux vomica L. seeds [16]. Several earlier studies have already revealed that brucine demonstrated anticancer properties against various cancers [17–19]. The synthesis of GO-functionalized chitosan (Ch)-brucine NCs and their biological activities have not been reported yet. Therefore, the current study aims at synthesizing and characterizing the GO, Ch, manganese, brucine, and folic acid (FA) functionalized NCs (GO/Mn/Ch/FA-Brucine NCs) and evaluating their anticancer potentials against liver cancer cells.
2 Materials and methods
2.1 Chemicals and reagents
The following chemicals, including GO, manganese nitrate, Ch, FA, and brucine (C23H26N2O4), were purchased from Sigma-Aldrich, USA. All assay kits to determine the biochemical parameters were acquired from Thermofisher and eBioscience, USA.
2.2 Synthesis of GO/Mn/Ch/FA-Brucine NCs
In 50 mL of distilled water, 500 mg of synthetic GO and 0.1 M of manganese(ii) nitrate hexahydrate (Mn(NO3)2·6H2O) were dissolved. The solution was then supplemented with 50 mL of distilled water, 0.5 g of Ch, and 1% acetic acid. To this mixture, 50 mg of brucine was added, followed by 100 mg of FA. NaOH (0.1 M) was then introduced drop-by-drop, and the suspension was heated with magnetic stirring for 6 h at 60°C. The resultant nanopowder was rinsed with ethanol and distilled water. To formulate GO/Mn/Ch/FA-Brucine NCs, we dried the precipitate at 120°C for 1 h, followed by annealing of the nanopowder at 200°C for 2 h.
2.3 Characterization of GO/Mn/Ch/FA-Brucine NCs
The UV-vis spectrophotometer (Shimadzu-1700, Japan) was used to analyze the synthesized GO/Mn/Ch/FA-Brucine NCs. The spectral characteristics of the NCs were analyzed within the wavelength range of 100–1,000 nm.
GO/Mn/Ch/FA-Brucine NCs were subjected to photoluminescence (PL) analysis using PL spectroscopy (F-2500 FL, Hitachi).
The X-ray diffraction (XRD) analysis was performed using the X’pert Pro PANalytical XRD machine. The NCs were examined and scanned for 0.02–0.5 s and a voltage of 40 kV and 45 mA.
The Fourier-transform infrared spectroscopy (FT-IR) study was conducted to investigate the stretching and bonding present in GO/Mn/Ch/FA-Brucine NCs. The NCs were analyzed using the Shimadzu-8400S (Japan) equipment. A spectrum of the NCs was acquired using the KBr disc technique at 4,000–500 cm−1.
The elemental profile of the NCs was analyzed using energy-dispersive X-ray spectroscopy (EDX), whereas their morphology and spatial distribution were analyzed using scanning electron microscopy (SEM) (Carl Zeiss Ultra 55 FESEM).
The transmission electron microscopy (TEM) analysis was conducted to examine the size and morphology of the NCs (TECNAI F30, USA). The copper grid holding the NCs was subjected to electronic radiation within a vacuum environment. Images of the samples were obtained using an electron beam.
The distribution and size of the NCs were examined using the Zeta sizer (Malvern, USA) dynamic light scattering (DLS) apparatus.
2.4 Antimicrobial activity
The well diffusion technique was employed to examine the antibacterial property of GO/Mn/Ch/FA-Brucine NCs against various pathogens, including Bacillus subtilis, Staphylococcus aureus, Proteus vulgaris, Klebsiella pneumoniae, Streptococcus pneumoniae, Escherichia coli, and Candida albicans [20]. Each strain was grown on an appropriate agar growth medium. Following the inoculation, the wells were developed on the agar surface using a sterile cork borer. Subsequently, the NCs were introduced into the wells at concentrations of 1, 1.5, and 2 μg·mL−1. The plates were incubated for 24 h, and the inhibitory zone diameter was then noted. Amoxicillin was used as a positive control.
2.5 Cell collection and maintenance
The liver cancer HepG2 and Hep-3B cells were collected from the ATCC, USA. Subsequently, the cells were grown in a CO2 incubator at 37°C, using Dulbecco’s modified eagle medium with 10% fetal bovine serum and 1% antimycotic mixtures. Upon reaching 80% confluency, the cells were subjected to trypsinization and used for further assays.
2.6 MTT assay
The assessment of HepG2 and Hep3B cell viability following treatment with GO/Mn/Ch/FA-Brucine NCs was conducted using the methylthiazolyldiphenyl-tetrazolium bromide assay [21]. Both cells were cultured separately in 96-well plates at a cell population of 5 × 103 cells/well for 24 h. Later, the cells were exposed to varying doses of the NCs (2, 4, 6, 8, 10, and 12 µg) for 24 h. Approximately 20 µL of MTT reagent was introduced to each well and incubated for 4 h. The developed formazan deposits were subsequently liquefied in 100 µL of dimethyl sulfoxide, and the absorbance was recorded at 570 nm.
2.7 Dual staining
The dual staining technique [22] was used to assay the apoptotic cell death in HepG2 cells following treatment with GO/Mn/Ch/FA-Brucine NCs. The cells were grown on a 24-well plates for 24 h, with a cell population of 5 × 105 cells/well. The NCs were subsequently treated at concentrations of 6 and 8 µg for 24 h. Later, the cells were stained using acridine orange/ethidium bromide) dye (100 μg·mL−1, 1:1 ratio) for 5 min. Following the staining process, the fluorescence intensity was assessed using a fluorescent microscope.
2.8 Quantification of oxidative stress markers
The concentrations of thiobarbituric acid reactive substances (TBARS) and the antioxidants (glutathione [GSH], superoxide dismutase [SOD], and catalase [CAT]) in the cell lysates of both untreated and NC-treated HepG2 cells were quantified using commercially available assay kits. These assays were performed according to the suggested protocols provided by the kit’s manufacturer (ThermoFisher Scientific, USA).
2.9 Measurement of inflammatory marker levels
The levels of tumor necrosis factor alpha (TNF-α), nuclear factor Kappa-light-chain-enhancer of activated B cells (NF-κB), cyclooxygenase-2 (COX-2), and interleukin-6 (IL-6) in the cell lysates of both untreated and NC-treated HepG2 cells were measured using the assay kits. These assays were performed according to the suggested protocols provided by the kit’s manufacturer (ThermoFisher Scientific, USA).
2.10 Statistical analysis
Dara are illustrated as the mean ± SD of three individual measurements, which were examined using the GraphPad Prism software. The values of the treatment groups were analyzed using one-way ANOVA and Duncan’s multiple range test (DMRT) to measure significant variations, which was set at p < 0.05.
3 Results
3.1 Characterization of GO/Mn/Ch/FA-Brucine NCs
Figure 1a depicts the results of the UV-visible spectrum analysis for the synthesized GO/Mn/Ch/FA-Brucine NCs. The absorbance at several wavelengths (100–1,000 nm) revealed that the highest absorbance peaks occurred at 266 and 300 nm, verifying the NCs’ synthesis (Figure 1a).

UV-visible spectroscopy and PL analysis of the synthesized GO/Mn/Ch/FA-Brucine NCs. The analysis of absorbance at several wavelengths (100–1,000 nm) revealed that the highest absorbance peak occurred at 266 and 300 nm (a). The wavelengths at which the excitations of the synthesized GO/Mn/Ch/FA-Brucine NCs occurred were determined to be 369.90, 433.98, and 480.42 nm, respectively, which reveals the crystal mode, surface characteristics, and structural flaws shown by the synthesized GO/Mn/Ch/FA-Brucine NCs (b).
Figure 1b depicts the PL analysis of GO/Mn/Ch/FA-Brucine NCs. The excitations of the NCs occurred at 369.90, 433.98, and 480.42 nm. The PL spectrum provides information regarding the crystal mode, surface characteristics, and structural flaws of the NCs. The peaks at 369.90 nm suggest the recombination of free excitons. The green emission at the 433.98 nm peak can be because of the existence of interstitial oxygen vacancies. The green emission at 480.42 nm indicates that the NCs included a solitary ionized oxygen vacancy (Figure 1b).
The purity and crystalline nature of GO/Mn/Ch/FA-Brucine NCs were assessed through the XRD analysis (Figure 2a). The peaks corresponding to the crystalline form of the NCs were seen at specific crystallographic orientations, such as (222), (400), (440), and (622) (Figure 2a).

XRD and FT-IR analysis of the synthesized GO/Mn/Ch/FA-Brucine NCs. The peaks corresponding to the crystalline form of GO/Mn/Ch/FA-Brucine NCs were seen at specific crystallographic orientations, such as (222), (400), (440), and (622) (a). The FT-IR analysis revealed the occurrence of the specific functional groups present in the synthesized GO/Mn/Ch/FA-Brucine NCs (b).
The FT-IR study was conducted to analyze the specific functional groups in GO/Mn/Ch/FA-Brucine NCs. The outcomes of this study are depicted in Figure 2b. The FT-IR spectra of the GO/Mn/Ch/FA-Brucine NCs exhibited a diverse range of peaks distributed across different frequencies. Major peaks at 3,565 and 3,468 cm−1 may be due to the vibrational band arising from the stretching motion of the O–H bond. The peaks at 2,922, 2,513, 2,444, and 2,142 cm−1 indicate the hydroxyl stretching. The peaks at 1,771, 1,618, 1,538, 1,420, 1,361, and 1,064 cm−1 correspond to the bending vibrations of C–H and C–O bonds, respectively. The peaks at 901, 842, 599, and 456 cm−1 correspond to H–O bonds.
The structure and appearance of the NCs were assessed using SEM, whereas their elemental constituents were determined using EDX spectroscopic analysis. The SEM microphotographs (Figure 3a) revealed that the NCs exhibited tetragonal and agglomerated morphological characteristics. The EDX analysis on the NCs revealed distinct peaks, suggesting the existence of carbon, nitrogen, and oxygen elements (Figure 3b).

SEM and EDX analysis of the synthesized GO/Mn/Ch/FA-Brucine NCs. The SEM images revealed that the GO/Mn/Ch/FA-Brucine NCs exhibited tetragonal and agglomerated morphological characteristics (a). EDX analysis of the GO/Mn/Ch/FA-Brucine NCs showed different peaks, which suggests that carbon, nitrogen, and oxygen are present (b).
The TEM images of GO/Mn/Ch/FA-Brucine NCs (Figure 4) revealed that the NCs exhibited cuboidal morphologies with an average diameter of 63 nm. The crystallization of the NCs was confirmed by examining selected area electron diffraction (SAED) patterns.

TEM analysis of the synthesized GO/Mn/Ch/FA-Brucine NCs. The TEM images revealed that the fabricated GO/Mn/Ch/FA-Brucine NCs exhibited cuboidal morphologies with an average diameter of 63 nm. The validation of the crystallization of the GO/Mn/Ch/FA-Brucine NCs was confirmed through the examination of the SAED patterns.
The DLS analysis was used to investigate the dispersion and particle size of the NCs (Figure 5), and the results revealed a reduced dispersion pattern with an average particle size of 136.20 nm.

DLS analysis of the synthesized GO/Mn/Ch/FA-Brucine NCs. The findings from the DLS study revealed a reduced dispersion pattern with an average particle size of 136.20 nm.
3.2 Antimicrobial effects of GO/Mn/Ch/FA-Brucine NCs
The well diffusion technique was used to analyze the antimicrobial effects of GO/Mn/Ch/FA-Brucine NCs against several pathogens, including B. subtilis, S. aureus, P. vulgaris, K. pneumoniae, S. pneumoniae, E. coli, and C. albicans (Figure 6). The NC treatment with varying concentrations exhibited remarkable antimicrobial efficacy against all examined pathogens, corroborating the results observed with amoxicillin. The growth of several pathogens, particularly E. coli, S. aureus, and C. albicans, was effectively suppressed by GO/Mn/Ch/FA-Brucine NCs. This suppression was demonstrated by the highest inhibition zone observed in these pathogens when exposed to the NCs (Figure 7).
Antimicrobial activity of the synthesized GO/Mn/Ch/FA-Brucine NCs. The treatment of various concentrations of the synthesized GO/Mn/Ch/FA-Brucine NCs effectively decreased the growth of tested pathogens, particularly E. coli, S. aureus, and C. albicans, which were more sensitive to the NCs.

Antimicrobial activity of the synthesized GO/Mn/Ch/FA-Brucine NCs. The data were given as a mean ± SD of triplicates. The results were statistically studied by one-way ANOVA and DMRT assays using the GraphPad Prism software. Values not sharing common superscript and data were significantly different from control at p < 0.01.
3.3 Effect of GO/Mn/Ch/FA-Brucine NCs on the HepG2 and Hep3B cell viability
The cytotoxic effects of GO/Mn/Ch/FA-Brucine NCs on HepG2 and HepB3 cells are shown in Figure 8. The NC treatment with varying doses (2, 4, 6, 8, 10, and 12 µg) considerably decreased the proliferative capacity of HepG2 and Hep3B cells. At higher concentrations of GO/Mn/Ch/FA-Brucine NCs, cell viability was markedly decreased in HepG2 cells than in Hep3B cells. The IC50 value of GO/Mn/Ch/FA-Brucine NCs for HepG2 cells was 6 µg; therefore, 6 and 8 µg were selected as IC50 and high doses of the NC for further assays, respectively.

Effect of GO/Mn/Ch/FA-Brucine NCs on the viability of HepG2 and Hep3B cells. The data were given as a mean ± SD of triplicates. The results were statistically studied by one-way ANOVA and DMRT assays using the GraphPad Prism software. Values not sharing common superscript significantly differ from control at p < 0.01.
3.4 Effect of GO/Mn/Ch/FA-Brucine NCs on the apoptosis in HepG2 cells
The findings of the dual staining analysis of apoptotic cell death are indicated in Figure 9. The NC treatment at 6 and 8 µg resulted in more yellow and orange fluoresced cells, respectively, than the untreated cells. The green fluoresced cells in the control well represent normal viable cells, whereas the increased yellow and orange fluoresced cells in the NC-treated wells indicate the existence of more early and late apoptotic cells, respectively.

Effect of GO/Mn/Ch/FA-Brucine NCs on the apoptosis in the HepG2 cells. The GO/Mn/Ch/FA-Brucine NCs-treated HepG2 cells demonstrated a higher number of cells with yellow and orange fluorescence, which represent the occurrence of apoptotic events. Magnification: 20×; scale bar: 50 µm.
3.5 Effect of GO/Mn/Ch/FA-Brucine NCs on the oxidative and antioxidative biomarkers in HepG2 cells
The NC treatment on the levels of TBARS and antioxidants (GSH, CAT, and SOD) in HepG2 cells are depicted in Figure 10. The NC treatment of HepG2 cells at 6 and 8 µg considerably increased the TBARS levels. Furthermore, the NCs at 6 and 8 µg effectively reduced the GSH, CAT, and SOD levels in HepG2 cells. There was a considerable reduction in antioxidants and an upsurge in oxidative stress upon the NC treatment with HepG2 cells (Figure 10).

Effect of GO/Mn/Ch/FA-Brucine NCs on the oxidative and antioxidative biomarkers in the HepG2 cells. The data were given as a mean ± SD of triplicates. The results were statistically studied by one-way ANOVA and DMRT assays using the GraphPad Prism software. “**” denotes that values are significantly different from control at p < 0.01.
3.6 Effect of GO/Mn/Ch/FA-Brucine NCs on the inflammatory marker levels in the HepG2 cells
The levels of inflammatory markers (TNF-α, NF-κB, COX-2, and IL-6) were evaluated in untreated and NC-treated HepG2 cells (Figure 11). Compared with the control cells, the NC treatment at 6 and 8 µg significantly decreased the levels of TNF-α, NF-κB, COX-2, and IL-6 in HepG2 cells.

Effect of GO/Mn/Ch/FA-Brucine NCs on the inflammatory marker levels in the HepG2 cells. The data were given as a mean ± SD of triplicates. The results were statistically studied by one-way ANOVA and DMRT assays using the GraphPad Prism software. “**” denotes that values are significantly different from control at p < 0.01.
4 Discussion
Nanomedicine employs nanomaterials and nanotechnology to develop novel pharmaceuticals and delivery mechanisms with the aim of enhancing the effectiveness of current therapeutic approaches. Nanomedicines possess several advantageous characteristics in the field of cancer research, including their diminutive size and remarkable drug release profiles. These attributes give them significant capacity to address the limitations associated with existing chemotherapeutic treatments. Significantly, nanomaterials have the ability to enhance the effectiveness of chemotherapeutic drug-loaded therapies and mitigate the adverse effects of these drugs by accurate targeting [23]. There is evidence supporting the enhanced therapeutic effectiveness and reduced adverse effects of anticancer treatments through the utilization of nanomaterial-based drug delivery systems [24]. Various challenges, such as limited ability to penetrate tumors, non-specific accumulation in tissues, premature release of drugs into tissues, and uncontrolled drug release at the intended site, can be addressed through the utilization of drug delivery systems that have been effectively studied in human and animal models [25].
Chemotherapeutic treatments involve the administration of drugs through injection or ingestion, which exert their effects throughout the body. Nevertheless, significant efforts have been dedicated by the pharmaceutical sector toward the advancement of methodologies that enhance the selectivity of anti-cancer medications, thereby minimizing the adverse effects associated with systemic therapy [26]. In the present scenario, the functionalization of nanocarrier surfaces has emerged as a feasible option to enhance the efficiency of drug delivery to targeted locations and minimize the dosage of delivered pharmaceuticals. Promising outcomes were achieved by the utilization of screening tests conducted both in vitro and in vivo, employing nanomaterials that were functionalized with several active constituents such as Ch and FA. FA is a chemical that has a strong binding affinity for tumor cells, thereby facilitating the uptake of nanomaterials [27].
The potential for reduced toxicity and wide-ranging applicability makes it a promising agent for drug delivery and anticancer purposes [28]. The evaluation of the toxicity of a drug candidate is highly recommended in the clinical environment of cancer treatment due to its time-consuming and complex nature [29]. Therefore, in this study, the cytotoxicity of the synthesized GO/Mn/Ch/FA-Brucine NCs was evaluated against HepG2 and Hep3B cells. The findings of the MTT assay confirmed that the GO/Mn/Ch/FA-Brucine NCs treatment substantially diminished the growth of both HepG2 and Hep3B cells, which evidence the cytotoxicity of GO/Mn/Ch/FA-Brucine NCs to liver cancer cells.
Apoptosis, often known as programmed cell death, is of utmost importance to the cell cycle mechanisms and is characterized by nuclear fragmentation, cell shrinkage, mRNA degradation, DNA fragmentation, and the formation of membrane-bound protrusions known as blebs [30]. Apoptosis serves as the principal mechanism that plays a pivotal role in regulating cellular homeostasis by regulating cell growth and death, thereby preventing the development of uncontrolled cellular proliferation, commonly known as cancer [31]. The deregulation of apoptosis has profound implications for the growth of cancer. The variation between the rate of cell proliferation and cell death is widely recognized as a defining characteristic of malignant tumors [32]. Hence, it is imperative to maintain cellular homeostasis by balancing the rates of cell growth and cell death in order to support regular physiological functions. The development of novel therapeutic approaches that specifically target the apoptotic process in cancer treatment is a promising technique. The current results proved that treatment with synthesized GO/Mn/Ch/FA-Brucine NCs effectively induced apoptotic cell death in the HepG2 cells.
Cells undergoing apoptosis exhibit the formation of large vesicles, known as apoptotic bodies, which contain a distinct phospholipid known as phosphatidylserine. This phospholipid serves as a signaling molecule, effectively alerting adjacent cells, which is characterized as an early apoptotic mechanism. Late apoptosis is a state that is irreversible in nature and is distinguished by the full disaggregation of the cytoskeleton, permeation of the cell, and disintegration. The benefits of inducing apoptosis in cancer cells depend on the ability to prevent an inflammatory reactions [33]. Apoptotic bodies are generated as a result of the apoptotic process and are utilized by phagocytic cells, which play a crucial role in preventing cancer cell growth [34]. The findings of the dual staining assay revealed the occurrence of apoptotic cell death in the GO/Mn/Ch/FA-Brucine NCs-treated HepG2 cells with distinct morphological changes.
The metabolic level of tumor cells are higher than those of non-malignant cells, mostly due to their rapid proliferation rate. As a result, there was an increase in the generation of reactive oxygen species (ROS) and other free radicals. The significance of ROS in cancer cell metabolism is of utmost importance. Over accumulation of endogenous ROS can contribute to the growth of cancer by causing DNA impairments and cellular metabolic reprogramming [35]. The secretion of antioxidant enzymes from the cell was primarily aimed at restoring balance to the increased levels of ROS. The enzyme known as SOD is synthesized by normal cells and is capable of transforming superoxide radicals into hydrogen peroxide. The overexpression of SOD and CAT has the ability to provide protection to tumor cells against an excessive accumulation of ROS [36].
GSH is a crucial thiol-dependent antioxidant that plays a significant role in the protection against oxidative damage [37]. GSH is widely recognized as a pivotal regulator of cellular homeostasis as well as being involved in the processes of DNA replication and repair. A potential cause for the decrease in GSH concentration could be attributed to the process of glutathione oxidation, which occurs due to oxidative stress. The present study observed a substantial decrease in SOD, CAT, and GSH contents in HepG2 cells treated with GO/Mn/Ch/FA-Brucine NCs compared to the control. The outcomes of this work align with the observations made in NPs-treated cancer cell lines [38].
Inflammation is a fundamental part of the innate immune system, characterized by the mobilization and stimulation of immune cells along with the involvement of soluble mediators such as cytokines and chemokines. The inflammatory process has conventionally served as a primary mechanism of host defense against detrimental stimuli. In addition to its conventional function, inflammation has been found to have a significant association with cancer, as evidenced by comprehensive examinations of tumor transcriptomes. These analyses have unveiled a unique expression pattern of inflammatory cytokines and the presence of recruited immune cells in various types of tumors [39]. The current understanding in the scientific community is that inflammation serves a substantial role in the tumor growth. The immune system plays a pivotal role in both facilitating and inhibiting various phases of tumor, and influencing the prognosis and treatment outcomes associated with cancer. Chronic inflammation, which precedes tumor growth and facilitates the development of cancer, has been identified as a contributing factor in some types of cancer [40].
Inflammatory cytokines like IL-6 and TNF-α promote the multiplication of cancer cells during the progression of a tumor. Additionally, many cytokines can act in opposition to the immune cells involved in anti-tumor responses [41]. TNF-α has been observed to facilitate the stimulation, differentiation, viability, or apoptosis of neoplastic cells within particular contexts. Furthermore, it has been observed that it exerts regulatory control over immunological and inflammatory responses [42]. The NF-κB transcription factors play pivotal roles in the process of carcinogenesis. The NF-κB pathway, when abnormally activated, has a crucial role in promoting tumor cell survival, inhibiting apoptosis, and promoting angiogenesis, hence facilitating the metastasis of malignancies to distant sites [43]. The inhibition of COX expression holds potential as a therapeutic approach for tumorigenesis. It was reported that inhibitors of COX exhibit cytotoxic effects on tumor cells by promoting apoptotic processes [44]. The results of this study highlighted that the GO/Mn/Ch/FA-Brucine NCs treatment effectively decreased the inflammatory markers in the HepG2 cells and facilitated apoptosis.
5 Conclusion
The present work showed that the GO/Mn/Ch/FA-Brucine NCs inhibited growth and induced apoptosis in liver cancer HepG2 cells. The NCs have shown significant effects in inhibiting viability, enhancing the cellular response to oxidative stress, and inducing apoptosis in the HepG2 cell line. The NCs also exhibited excellent antimicrobial activity. Therefore, our findings suggest that GO/Mn/Ch/FA-Brucine NCs are potential therapeutic agents to treat liver cancer. However, future research studies are needed to acquire a complete understanding of the precise molecular pathways underlying the anticancer properties of the NCs in the context of liver cancer.
-
Funding information: Authors state no funding involved.
-
Author contributions: Mohd Fahami Nur Azlina and Naiyer Shahzad: writing – original draft, writing – review and editing, formal analysis; Ibrahim M. Alanazi: writing – original draft, formal analysis; Ibrahim Abdel Aziz Ibrahim and Abdullah R. Alzahrani: supervision, conceptualization, visualization, and project administration; Palanisamy Arulselvan and Yusof Kamisah: writing – reviewing and editing; Imran Shahid and Nafeeza Mohd Ismail: methodology, formal analysis.
-
Conflict of interest: Authors state no conflict of interest.
-
Data availability statement: All data generated or analyzed during this study are included in this published article.
References
[1] Agnihotri A. Liver cancer deaths are expected to rise by more than 55% by 2040: research. Health-Hindustan times; 2022.Search in Google Scholar
[2] Siegel RL, Miller KD, Wagle NS, Jemal A. Cancer statistics 2023. CA Cancer J Clin. 2023;73:17–48.10.3322/caac.21763Search in Google Scholar PubMed
[3] Kirtonia A, Gala K, Fernandes SG, Pandya G, Pandey AK, Sethi G, et al. Repurposing of drugs: An attractive pharmacological strategy for cancer therapeutics. Semin Cancer Biol. 2021;68:258–78.10.1016/j.semcancer.2020.04.006Search in Google Scholar PubMed
[4] Paskeh MDA, Ghadyani F, Hashemi M, Abbaspour A, Zabolian A, Javanshir S, et al. Biological impact and therapeutic perspective of targeting PI3K/Akt signaling in hepatocellular carcinoma: promises and challenges. Pharmacol Res. 2022;187:106553.10.1016/j.phrs.2022.106553Search in Google Scholar PubMed
[5] Cassinotto C, Nogue E, Durand Q, Panaro F, Assenat E, Dohan A, et al. Life expectancy of patients with hepatocellular carcinoma according to the upfront treatment: a nationwide analysis. Diagn Interv Imaging. 2023;104:192–9.10.1016/j.diii.2023.01.002Search in Google Scholar PubMed
[6] Dehshahri A, Ashrafizadeh M, Ghasemipour Afshar E, Pardakhty A, Mandegary A, Mohammadinejad R, et al. Topoisomerase inhibitors: pharmacology and emerging nanoscale delivery systems. Pharmacol Res. 2020;151:104551.10.1016/j.phrs.2019.104551Search in Google Scholar PubMed
[7] Lodhi MS, Khan MT, Aftab S, Samra ZQ, Wang H, Wei DQ. A novel formulation of theranostic nanomedicine for targeting drug delivery to gastrointestinal tract cancer. Cancer Nanotechnol. 2021;12(1):1–27.10.1186/s12645-021-00098-4Search in Google Scholar
[8] Tang Z, Gao H, Chen X, Zhang Y, Li A, Wang G. Advanced multifunctional composite phase change materials based on photo‐responsive materials. Nano Energy. 2021;80:105454.10.1016/j.nanoen.2020.105454Search in Google Scholar
[9] Herdiana Y, Wathoni N, Shamsuddin S, Joni IM, Muchtaridi M. Chitosan-based nanoparticles of targeted drug delivery system in breast cancer treatment. Polymers (Basel). 2021;13(11):1717.10.3390/polym13111717Search in Google Scholar PubMed PubMed Central
[10] Tinajero-Díaz E, Salado-Leza D, Gonzalez C, Martínez Velázquez M, López Z, Bravo-Madrigal J, et al. Green metallic nanoparticles for cancer therapy: evaluation models and cancer applications. Pharmaceutics. 2021;13(10):1719.10.3390/pharmaceutics13101719Search in Google Scholar PubMed PubMed Central
[11] Lee J, Yim Y, Kim S, Choi M-H, Choi B-S, Lee Y, et al. In-depth investigation of the interaction between DNA and nano-sized graphene oxide. Carbon. 2016;97:92–988.10.1016/j.carbon.2015.07.093Search in Google Scholar
[12] Park J, Kim B, Han J, Oh J, Park S, Ryu S, et al. Graphene oxide flakes as a cellular adhesive: prevention of reactive oxygen species mediated death of implanted cells for cardiac repair. ACS Nano. 2015;9(5):4987–99.10.1021/nn507149wSearch in Google Scholar PubMed
[13] Xu Z, Wang S, Li Y, Wang M, Shi P, Huang X. Covalent functionalization of graphene oxide with biocompatible poly(ethyleneglycol) for delivery of paclitaxel. ACS Appl Mater Interfaces. 2014;6:17268–76.10.1021/am505308fSearch in Google Scholar PubMed
[14] Cao L, Zhang F, Wang Q, Wu X. Fabrication of chitosan/graphene oxide polymer nanofiber and its biocompatiility for cartilage tissue engineering. Mater Sci Eng C. 2017;79:697–701.10.1016/j.msec.2017.05.056Search in Google Scholar PubMed
[15] Nogueira E, Freitas J, Loureiro A, Nogueira P, Gomes AC, Preto A, et al. Neutral PEGlated liposomal formulation for efficient folate-mediated delivery of MCL1 siRNA to activated macrophages. Colloid Surf B. 2017;155:459–65.10.1016/j.colsurfb.2017.04.023Search in Google Scholar PubMed
[16] Lu L, Huang R, Wu Y, Jin JM, Chen HZ, Zhang LJ, et al. Brucine: a review of phytochemistry, pharmacology, and toxicology. Fron Pharmacol. 2020;11:377.10.3389/fphar.2020.00377Search in Google Scholar PubMed PubMed Central
[17] Li M, Li P, Zhang M, Ma F. Brucine suppresses breast cancer metastasis via inhibiting epithelial mesenchymal transition and matrix metalloproteinases expressions. Chin J Integr Med. 2018;24:40–6.10.1007/s11655-017-2805-1Search in Google Scholar PubMed
[18] Shi X, Zhu M, Kang Y, Yang T, Chen X, Zhang Y. Wnt/β-catenin signaling pathway is involved in regulating the migration by an effective natural compound brucine in LoVo cells. Phytomedicine. 2018;46:85–92.10.1016/j.phymed.2018.04.019Search in Google Scholar PubMed
[19] Yan W, Zeng Z, Qin F, Xu J, Liao Z, Ouyang M. Effects of brucine on mitochondrial apoptosis and expression of HSP70 in prostate cancer cells. Transl Cancer Res. 2022;11(3):500–7.10.21037/tcr-22-209Search in Google Scholar PubMed PubMed Central
[20] CLSI, Performance Standards for Antimicrobial Disk Susceptibility Tests, Approved Standard, 7th ed., CLSI document M02-A11. Clinical and Laboratory Standards Institute, 950 West Valley Road, Suite 2500, Wayne, Pennsylvania 19087, USA; 2012.Search in Google Scholar
[21] Mosmann T. Rapid colorimetric assay for cellular growth and survival: application to proliferation and cytotoxicity assays. J Immunol Methods. 1983;65(1–2):55–63.10.1016/0022-1759(83)90303-4Search in Google Scholar PubMed
[22] Taatjes DJ, Wadsworth MP, Zaman AK, Schneider DJ, Sobel BE. A novel dual staining method for identification of apoptotic cells reveals a modest apoptotic response in infarcted mouse myocardium. Histochem Cell Biol. 2007;128(3):275–83.10.1007/s00418-007-0323-5Search in Google Scholar PubMed
[23] Thakur AK, Chellappan DK, Dua K, Mehta M, Satija S, Singh I. Patented therapeutic drug delivery strategies for targeting pulmonary diseases. Expert Opin Ther Pat. 2020;30(5):375–87.10.1080/13543776.2020.1741547Search in Google Scholar PubMed
[24] Sharma A, Shambhwani D, Pandey S, Singh J, Lalhlenmawia H, Kumarasamy M, et al. Advances in lung cancer treatment using nanomedicines. ACS Omega. 2022;8(1):10–41.10.1021/acsomega.2c04078Search in Google Scholar PubMed PubMed Central
[25] Gai S, Yang G, Yang P, He F, Lin J, Jin D, et al. Recent advances in functional nanomaterials for light‐triggered cancer therapy. Nano Today. 2018;19:146–87.10.1016/j.nantod.2018.02.010Search in Google Scholar
[26] Thapa RK, Choi Y, Jeong JH, Youn YS, Choi HG, Yong CS, et al. Folate-mediated targeted delivery of combination chemoterapeutics loaded reduced graphene oxide for synergistic chemophotothermal therapy of cancer. Pharm Res. 2016;33:2816–27.10.1007/s11095-016-2007-0Search in Google Scholar PubMed
[27] Marino FZ, Ronchi A, Accardo M, Franco R. Detection of folate receptorpositive circulating tumor cells by ligand-targeted polymerase chain reaction in non-small cell lung cancer patients. J Thorac Dis. 2016;8:1437–9.10.21037/jtd.2016.05.38Search in Google Scholar PubMed PubMed Central
[28] Khursheed R, Dua K, Vishwas S, Gulati M, Jha NK, Aldhafeeri GM, et al. Biomedical applications of metallic nanoparticles in cancer: current status and future perspectives. Biomed Pharmacother. 2022;150:112951.10.1016/j.biopha.2022.112951Search in Google Scholar PubMed
[29] Lin L, Cheng K, Xie Z, Chen C, Chen L, Huang Y, et al. Purification and characterization a polysaccharide from Hedyotis diffusa and its apoptosis inducing activity toward human lung cancer cell line A549. Int J Biol Macromol. 2019;122:64–71.10.1016/j.ijbiomac.2018.10.077Search in Google Scholar PubMed
[30] Morana O, Wood W, Gregory CD. The apoptosis paradox in cancer. Int J Mol Sci. 2022;23:1328.10.3390/ijms23031328Search in Google Scholar PubMed PubMed Central
[31] Yamaguchi Y, Shiraki K, Fuke H, Inoue T, Miyashita K, Yamanaka Y, et al. Targeting of X-linked inhibitor of apoptosis protein or Survivin by short interfering RNAs sensitises hepatoma cells to TNF-related apoptosis-inducing ligand- and chemotherapeutic agent-induced cell death. Oncol Rep. 2005;12:1211–316.10.3892/or.14.5.1311Search in Google Scholar
[32] Giorgi C, Romagnoli A, Pinton P, Rizzuto R. Ca2 + signaling, mitochondria and cell death. Curr Mol Med. 2008;8(2):119–30.10.2174/156652408783769571Search in Google Scholar PubMed
[33] Elmore S. Apoptosis: a review of programmed cell death. Toxicol Pathol. 2007;35(4):495–516.10.1080/01926230701320337Search in Google Scholar PubMed PubMed Central
[34] Kroemer G, El-Deiry WS, Golstein P, Peter ME, Vaux D, Vandenabeele P, et al. Classification of cell death: recommendations of the nomenclature committee on cell death. Cell Death Differ. 2005;12:1463–7.10.1038/sj.cdd.4401724Search in Google Scholar PubMed
[35] Panieri E, Santoro MM. Ros homeostasis and metabolism: a dangerous liason in cancer cells. Cell Death Dis. 2016;7:e2253.10.1038/cddis.2016.105Search in Google Scholar PubMed PubMed Central
[36] Glorieux C, Calderon PB. Catalase down-regulation in cancer cells exposed to arsenic trioxide is involved in their increased sensitivity to a pro-oxidant treatment. Cancer Cell Int. 2018;18:24.10.1186/s12935-018-0524-0Search in Google Scholar PubMed PubMed Central
[37] Kretowski R, Jabłońska-Trypuć A, Cechowska-Pasko M. The preliminary study on the proapoptotic effect of reduced graphene oxide in breast cancer cell lines. Int J Mol Sci. 2021;22:12593.10.3390/ijms222212593Search in Google Scholar PubMed PubMed Central
[38] Shiny P, Mukherjee A, Chandrasekaran N. Haemocompatibility assessment of synthesised platinum nanoparticles and its implication in biology. Bioproc Biosyst Eng. 2014;37(6):991–7.10.1007/s00449-013-1069-1Search in Google Scholar PubMed
[39] Binnewies M, Roberts EW, Kersten K, Chan V, Fearon DF, Merad M, et al. Understanding the tumor immune microenvironment (TIME) for effective therapy. Nat Med. 2018;24:541–50.10.1038/s41591-018-0014-xSearch in Google Scholar PubMed PubMed Central
[40] Greten FR, Grivennikov SI. Inflammation and cancer: triggers, mechanisms, and consequences. Immunity. 2019;51:27–41.10.1016/j.immuni.2019.06.025Search in Google Scholar PubMed PubMed Central
[41] Suarez-Carmona M, Lesage J, Cataldo D, Gilles C. EMT and inflammation: Inseparable actors of cancer progression. Mol Oncol. 2017;11:805–23.10.1002/1878-0261.12095Search in Google Scholar PubMed PubMed Central
[42] Desplat-Jégo S, Burkly L, Putterman C. Targeting TNF and its family members in autoimmune/inflammatory disease. Mediators Inflamm. 2014;2014:628748.10.1155/2014/628748Search in Google Scholar PubMed PubMed Central
[43] Xia Y, Shen S, Verma IM. NF-κB, an active player in human cancers. Cancer Immunol Res. 2014;2:823–30.10.1158/2326-6066.CIR-14-0112Search in Google Scholar PubMed PubMed Central
[44] Szweda M, Rychlik A, Babińska I, Pomianowski A. Cyclooxygenase-2 as a biomarker with diagnostic, therapeutic, prognostic, and predictive relevance in small animal oncology. J Vet Res. 2020 Mar;64(1):151–60.10.2478/jvetres-2020-0018Search in Google Scholar PubMed PubMed Central
© 2024 the author(s), published by De Gruyter
This work is licensed under the Creative Commons Attribution 4.0 International License.
Articles in the same Issue
- Research Articles
- Green polymer electrolyte and activated charcoal-based supercapacitor for energy harvesting application: Electrochemical characteristics
- Research on the adsorption of Co2+ ions using halloysite clay and the ability to recover them by electrodeposition method
- Simultaneous estimation of ibuprofen, caffeine, and paracetamol in commercial products using a green reverse-phase HPTLC method
- Isolation, screening and optimization of alkaliphilic cellulolytic fungi for production of cellulase
- Functionalized gold nanoparticles coated with bacterial alginate and their antibacterial and anticancer activities
- Comparative analysis of bio-based amino acid surfactants obtained via Diels–Alder reaction of cyclic anhydrides
- Biosynthesis of silver nanoparticles on yellow phosphorus slag and its application in organic coatings
- Exploring antioxidant potential and phenolic compound extraction from Vitis vinifera L. using ultrasound-assisted extraction
- Manganese and copper-coated nickel oxide nanoparticles synthesized from Carica papaya leaf extract induce antimicrobial activity and breast cancer cell death by triggering mitochondrial caspases and p53
- Insight into heating method and Mozafari method as green processing techniques for the synthesis of micro- and nano-drug carriers
- Silicotungstic acid supported on Bi-based MOF-derived metal oxide for photodegradation of organic dyes
- Synthesis and characterization of capsaicin nanoparticles: An attempt to enhance its bioavailability and pharmacological actions
- Synthesis of Lawsonia inermis-encased silver–copper bimetallic nanoparticles with antioxidant, antibacterial, and cytotoxic activity
- Facile, polyherbal drug-mediated green synthesis of CuO nanoparticles and their potent biological applications
- Zinc oxide-manganese oxide/carboxymethyl cellulose-folic acid-sesamol hybrid nanomaterials: A molecularly targeted strategy for advanced triple-negative breast cancer therapy
- Exploring the antimicrobial potential of biogenically synthesized graphene oxide nanoparticles against targeted bacterial and fungal pathogens
- Biofabrication of silver nanoparticles using Uncaria tomentosa L.: Insight into characterization, antibacterial activities combined with antibiotics, and effect on Triticum aestivum germination
- Membrane distillation of synthetic urine for use in space structural habitat systems
- Investigation on mechanical properties of the green synthesis bamboo fiber/eggshell/coconut shell powder-based hybrid biocomposites under NaOH conditions
- Green synthesis of magnesium oxide nanoparticles using endophytic fungal strain to improve the growth, metabolic activities, yield traits, and phenolic compounds content of Nigella sativa L.
- Estimation of greenhouse gas emissions from rice and annual upland crops in Red River Delta of Vietnam using the denitrification–decomposition model
- Synthesis of humic acid with the obtaining of potassium humate based on coal waste from the Lenger deposit, Kazakhstan
- Ascorbic acid-mediated selenium nanoparticles as potential antihyperuricemic, antioxidant, anticoagulant, and thrombolytic agents
- Green synthesis of silver nanoparticles using Illicium verum extract: Optimization and characterization for biomedical applications
- Antibacterial and dynamical behaviour of silicon nanoparticles influenced sustainable waste flax fibre-reinforced epoxy composite for biomedical application
- Optimising coagulation/flocculation using response surface methodology and application of floc in biofertilisation
- Green synthesis and multifaceted characterization of iron oxide nanoparticles derived from Senna bicapsularis for enhanced in vitro and in vivo biological investigation
- Potent antibacterial nanocomposites from okra mucilage/chitosan/silver nanoparticles for multidrug-resistant Salmonella Typhimurium eradication
- Trachyspermum copticum aqueous seed extract-derived silver nanoparticles: Exploration of their structural characterization and comparative antibacterial performance against gram-positive and gram-negative bacteria
- Microwave-assisted ultrafine silver nanoparticle synthesis using Mitragyna speciosa for antimalarial applications
- Green synthesis and characterisation of spherical structure Ag/Fe2O3/TiO2 nanocomposite using acacia in the presence of neem and tulsi oils
- Green quantitative methods for linagliptin and empagliflozin in dosage forms
- Enhancement efficacy of omeprazole by conjugation with silver nanoparticles as a urease inhibitor
- Residual, sequential extraction, and ecological risk assessment of some metals in ash from municipal solid waste incineration, Vietnam
- Green synthesis of ZnO nanoparticles using the mangosteen (Garcinia mangostana L.) leaf extract: Comparative preliminary in vitro antibacterial study
- Simultaneous determination of lesinurad and febuxostat in commercial fixed-dose combinations using a greener normal-phase HPTLC method
- A greener RP-HPLC method for quaternary estimation of caffeine, paracetamol, levocetirizine, and phenylephrine acquiring AQbD with stability studies
- Optimization of biomass durian peel as a heterogeneous catalyst in biodiesel production using microwave irradiation
- Thermal treatment impact on the evolution of active phases in layered double hydroxide-based ZnCr photocatalysts: Photodegradation and antibacterial performance
- Preparation of silymarin-loaded zein polysaccharide core–shell nanostructures and evaluation of their biological potentials
- Preparation and characterization of composite-modified PA6 fiber for spectral heating and heat storage applications
- Preparation and electrocatalytic oxygen evolution of bimetallic phosphates (NiFe)2P/NF
- Rod-shaped Mo(vi) trichalcogenide–Mo(vi) oxide decorated on poly(1-H pyrrole) as a promising nanocomposite photoelectrode for green hydrogen generation from sewage water with high efficiency
- Green synthesis and studies on citrus medica leaf extract-mediated Au–ZnO nanocomposites: A sustainable approach for efficient photocatalytic degradation of rhodamine B dye in aqueous media
- Cellulosic materials for the removal of ciprofloxacin from aqueous environments
- The analytical assessment of metal contamination in industrial soils of Saudi Arabia using the inductively coupled plasma technology
- The effect of modified oily sludge on the slurry ability and combustion performance of coal water slurry
- Eggshell waste transformation to calcium chloride anhydride as food-grade additive and eggshell membranes as enzyme immobilization carrier
- Synthesis of EPAN and applications in the encapsulation of potassium humate
- Biosynthesis and characterization of silver nanoparticles from Cedrela toona leaf extracts: An exploration into their antibacterial, anticancer, and antioxidant potential
- Enhancing mechanical and rheological properties of HDPE films through annealing for eco-friendly agricultural applications
- Immobilisation of catalase purified from mushroom (Hydnum repandum) onto glutaraldehyde-activated chitosan and characterisation: Its application for the removal of hydrogen peroxide from artificial wastewater
- Sodium titanium oxide/zinc oxide (STO/ZnO) photocomposites for efficient dye degradation applications
- Effect of ex situ, eco-friendly ZnONPs incorporating green synthesised Moringa oleifera leaf extract in enhancing biochemical and molecular aspects of Vicia faba L. under salt stress
- Biosynthesis and characterization of selenium and silver nanoparticles using Trichoderma viride filtrate and their impact on Culex pipiens
- Photocatalytic degradation of organic dyes and biological potentials of biogenic zinc oxide nanoparticles synthesized using the polar extract of Cyperus scariosus R.Br. (Cyperaceae)
- Assessment of antiproliferative activity of green-synthesized nickel oxide nanoparticles against glioblastoma cells using Terminalia chebula
- Chlorine-free synthesis of phosphinic derivatives by change in the P-function
- Anticancer, antioxidant, and antimicrobial activities of nanoemulsions based on water-in-olive oil and loaded on biogenic silver nanoparticles
- Study and mechanism of formation of phosphorus production waste in Kazakhstan
- Synthesis and stabilization of anatase form of biomimetic TiO2 nanoparticles for enhancing anti-tumor potential
- Microwave-supported one-pot reaction for the synthesis of 5-alkyl/arylidene-2-(morpholin/thiomorpholin-4-yl)-1,3-thiazol-4(5H)-one derivatives over MgO solid base
- Screening the phytochemicals in Perilla leaves and phytosynthesis of bioactive silver nanoparticles for potential antioxidant and wound-healing application
- Graphene oxide/chitosan/manganese/folic acid-brucine functionalized nanocomposites show anticancer activity against liver cancer cells
- Nature of serpentinite interactions with low-concentration sulfuric acid solutions
- Multi-objective statistical optimisation utilising response surface methodology to predict engine performance using biofuels from waste plastic oil in CRDi engines
- Microwave-assisted extraction of acetosolv lignin from sugarcane bagasse and electrospinning of lignin/PEO nanofibres for carbon fibre production
- Biosynthesis, characterization, and investigation of cytotoxic activities of selenium nanoparticles utilizing Limosilactobacillus fermentum
- Highly photocatalytic materials based on the decoration of poly(O-chloroaniline) with molybdenum trichalcogenide oxide for green hydrogen generation from Red Sea water
- Highly efficient oil–water separation using superhydrophobic cellulose aerogels derived from corn straw
- Beta-cyclodextrin–Phyllanthus emblica emulsion for zinc oxide nanoparticles: Characteristics and photocatalysis
- Assessment of antimicrobial activity and methyl orange dye removal by Klebsiella pneumoniae-mediated silver nanoparticles
- Influential eradication of resistant Salmonella Typhimurium using bioactive nanocomposites from chitosan and radish seed-synthesized nanoselenium
- Antimicrobial activities and neuroprotective potential for Alzheimer’s disease of pure, Mn, Co, and Al-doped ZnO ultra-small nanoparticles
- Green synthesis of silver nanoparticles from Bauhinia variegata and their biological applications
- Synthesis and optimization of long-chain fatty acids via the oxidation of long-chain fatty alcohols
- Eminent Red Sea water hydrogen generation via a Pb(ii)-iodide/poly(1H-pyrrole) nanocomposite photocathode
- Green synthesis and effective genistein production by fungal β-glucosidase immobilized on Al2O3 nanocrystals synthesized in Cajanus cajan L. (Millsp.) leaf extracts
- Green stability-indicating RP-HPTLC technique for determining croconazole hydrochloride
- Green synthesis of La2O3–LaPO4 nanocomposites using Charybdis natator for DNA binding, cytotoxic, catalytic, and luminescence applications
- Eco-friendly drugs induce cellular changes in colistin-resistant bacteria
- Tangerine fruit peel extract mediated biogenic synthesized silver nanoparticles and their potential antimicrobial, antioxidant, and cytotoxic assessments
- Green synthesis on performance characteristics of a direct injection diesel engine using sandbox seed oil
- A highly sensitive β-AKBA-Ag-based fluorescent “turn off” chemosensor for rapid detection of abamectin in tomatoes
- Green synthesis and physical characterization of zinc oxide nanoparticles (ZnO NPs) derived from the methanol extract of Euphorbia dracunculoides Lam. (Euphorbiaceae) with enhanced biosafe applications
- Detection of morphine and data processing using surface plasmon resonance imaging sensor
- Effects of nanoparticles on the anaerobic digestion properties of sulfamethoxazole-containing chicken manure and analysis of bio-enzymes
- Bromic acid-thiourea synergistic leaching of sulfide gold ore
- Green chemistry approach to synthesize titanium dioxide nanoparticles using Fagonia Cretica extract, novel strategy for developing antimicrobial and antidiabetic therapies
- Green synthesis and effective utilization of biogenic Al2O3-nanocoupled fungal lipase in the resolution of active homochiral 2-octanol and its immobilization via aluminium oxide nanoparticles
- Eco-friendly RP-HPLC approach for simultaneously estimating the promising combination of pentoxifylline and simvastatin in therapeutic potential for breast cancer: Appraisal of greenness, whiteness, and Box–Behnken design
- Use of a humidity adsorbent derived from cockleshell waste in Thai fried fish crackers (Keropok)
- One-pot green synthesis, biological evaluation, and in silico study of pyrazole derivatives obtained from chalcones
- Bio-sorption of methylene blue and production of biofuel by brown alga Cystoseira sp. collected from Neom region, Kingdom of Saudi Arabia
- Synthesis of motexafin gadolinium: A promising radiosensitizer and imaging agent for cancer therapy
- The impact of varying sizes of silver nanoparticles on the induction of cellular damage in Klebsiella pneumoniae involving diverse mechanisms
- Microwave-assisted green synthesis, characterization, and in vitro antibacterial activity of NiO nanoparticles obtained from lemon peel extract
- Rhus microphylla-mediated biosynthesis of copper oxide nanoparticles for enhanced antibacterial and antibiofilm efficacy
- Harnessing trichalcogenide–molybdenum(vi) sulfide and molybdenum(vi) oxide within poly(1-amino-2-mercaptobenzene) frameworks as a photocathode for sustainable green hydrogen production from seawater without sacrificial agents
- Magnetically recyclable Fe3O4@SiO2 supported phosphonium ionic liquids for efficient and sustainable transformation of CO2 into oxazolidinones
- A comparative study of Fagonia arabica fabricated silver sulfide nanoparticles (Ag2S) and silver nanoparticles (AgNPs) with distinct antimicrobial, anticancer, and antioxidant properties
- Visible light photocatalytic degradation and biological activities of Aegle marmelos-mediated cerium oxide nanoparticles
- Physical intrinsic characteristics of spheroidal particles in coal gasification fine slag
- Exploring the effect of tea dust magnetic biochar on agricultural crops grown in polycyclic aromatic hydrocarbon contaminated soil
- Crosslinked chitosan-modified ultrafiltration membranes for efficient surface water treatment and enhanced anti-fouling performances
- Study on adsorption characteristics of biochars and their modified biochars for removal of organic dyes from aqueous solution
- Zein polymer nanocarrier for Ocimum basilicum var. purpurascens extract: Potential biomedical use
- Green synthesis, characterization, and in vitro and in vivo biological screening of iron oxide nanoparticles (Fe3O4) generated with hydroalcoholic extract of aerial parts of Euphorbia milii
- Novel microwave-based green approach for the synthesis of dual-loaded cyclodextrin nanosponges: Characterization, pharmacodynamics, and pharmacokinetics evaluation
- Bi2O3–BiOCl/poly-m-methyl aniline nanocomposite thin film for broad-spectrum light-sensing
- Green synthesis and characterization of CuO/ZnO nanocomposite using Musa acuminata leaf extract for cytotoxic studies on colorectal cancer cells (HCC2998)
- Review Articles
- Materials-based drug delivery approaches: Recent advances and future perspectives
- A review of thermal treatment for bamboo and its composites
- An overview of the role of nanoherbicides in tackling challenges of weed management in wheat: A novel approach
- An updated review on carbon nanomaterials: Types, synthesis, functionalization and applications, degradation and toxicity
- Special Issue: Emerging green nanomaterials for sustainable waste management and biomedical applications
- Green synthesis of silver nanoparticles using mature-pseudostem extracts of Alpinia nigra and their bioactivities
- Special Issue: New insights into nanopythotechnology: current trends and future prospects
- Green synthesis of FeO nanoparticles from coffee and its application for antibacterial, antifungal, and anti-oxidation activity
- Dye degradation activity of biogenically synthesized Cu/Fe/Ag trimetallic nanoparticles
- Special Issue: Composites and green composites
- Recent trends and advancements in the utilization of green composites and polymeric nanocarriers for enhancing food quality and sustainable processing
- Retraction
- Retraction of “Biosynthesis and characterization of silver nanoparticles from Cedrela toona leaf extracts: An exploration into their antibacterial, anticancer, and antioxidant potential”
- Retraction of “Photocatalytic degradation of organic dyes and biological potentials of biogenic zinc oxide nanoparticles synthesized using the polar extract of Cyperus scariosus R.Br. (Cyperaceae)”
- Retraction to “Green synthesis on performance characteristics of a direct injection diesel engine using sandbox seed oil”
Articles in the same Issue
- Research Articles
- Green polymer electrolyte and activated charcoal-based supercapacitor for energy harvesting application: Electrochemical characteristics
- Research on the adsorption of Co2+ ions using halloysite clay and the ability to recover them by electrodeposition method
- Simultaneous estimation of ibuprofen, caffeine, and paracetamol in commercial products using a green reverse-phase HPTLC method
- Isolation, screening and optimization of alkaliphilic cellulolytic fungi for production of cellulase
- Functionalized gold nanoparticles coated with bacterial alginate and their antibacterial and anticancer activities
- Comparative analysis of bio-based amino acid surfactants obtained via Diels–Alder reaction of cyclic anhydrides
- Biosynthesis of silver nanoparticles on yellow phosphorus slag and its application in organic coatings
- Exploring antioxidant potential and phenolic compound extraction from Vitis vinifera L. using ultrasound-assisted extraction
- Manganese and copper-coated nickel oxide nanoparticles synthesized from Carica papaya leaf extract induce antimicrobial activity and breast cancer cell death by triggering mitochondrial caspases and p53
- Insight into heating method and Mozafari method as green processing techniques for the synthesis of micro- and nano-drug carriers
- Silicotungstic acid supported on Bi-based MOF-derived metal oxide for photodegradation of organic dyes
- Synthesis and characterization of capsaicin nanoparticles: An attempt to enhance its bioavailability and pharmacological actions
- Synthesis of Lawsonia inermis-encased silver–copper bimetallic nanoparticles with antioxidant, antibacterial, and cytotoxic activity
- Facile, polyherbal drug-mediated green synthesis of CuO nanoparticles and their potent biological applications
- Zinc oxide-manganese oxide/carboxymethyl cellulose-folic acid-sesamol hybrid nanomaterials: A molecularly targeted strategy for advanced triple-negative breast cancer therapy
- Exploring the antimicrobial potential of biogenically synthesized graphene oxide nanoparticles against targeted bacterial and fungal pathogens
- Biofabrication of silver nanoparticles using Uncaria tomentosa L.: Insight into characterization, antibacterial activities combined with antibiotics, and effect on Triticum aestivum germination
- Membrane distillation of synthetic urine for use in space structural habitat systems
- Investigation on mechanical properties of the green synthesis bamboo fiber/eggshell/coconut shell powder-based hybrid biocomposites under NaOH conditions
- Green synthesis of magnesium oxide nanoparticles using endophytic fungal strain to improve the growth, metabolic activities, yield traits, and phenolic compounds content of Nigella sativa L.
- Estimation of greenhouse gas emissions from rice and annual upland crops in Red River Delta of Vietnam using the denitrification–decomposition model
- Synthesis of humic acid with the obtaining of potassium humate based on coal waste from the Lenger deposit, Kazakhstan
- Ascorbic acid-mediated selenium nanoparticles as potential antihyperuricemic, antioxidant, anticoagulant, and thrombolytic agents
- Green synthesis of silver nanoparticles using Illicium verum extract: Optimization and characterization for biomedical applications
- Antibacterial and dynamical behaviour of silicon nanoparticles influenced sustainable waste flax fibre-reinforced epoxy composite for biomedical application
- Optimising coagulation/flocculation using response surface methodology and application of floc in biofertilisation
- Green synthesis and multifaceted characterization of iron oxide nanoparticles derived from Senna bicapsularis for enhanced in vitro and in vivo biological investigation
- Potent antibacterial nanocomposites from okra mucilage/chitosan/silver nanoparticles for multidrug-resistant Salmonella Typhimurium eradication
- Trachyspermum copticum aqueous seed extract-derived silver nanoparticles: Exploration of their structural characterization and comparative antibacterial performance against gram-positive and gram-negative bacteria
- Microwave-assisted ultrafine silver nanoparticle synthesis using Mitragyna speciosa for antimalarial applications
- Green synthesis and characterisation of spherical structure Ag/Fe2O3/TiO2 nanocomposite using acacia in the presence of neem and tulsi oils
- Green quantitative methods for linagliptin and empagliflozin in dosage forms
- Enhancement efficacy of omeprazole by conjugation with silver nanoparticles as a urease inhibitor
- Residual, sequential extraction, and ecological risk assessment of some metals in ash from municipal solid waste incineration, Vietnam
- Green synthesis of ZnO nanoparticles using the mangosteen (Garcinia mangostana L.) leaf extract: Comparative preliminary in vitro antibacterial study
- Simultaneous determination of lesinurad and febuxostat in commercial fixed-dose combinations using a greener normal-phase HPTLC method
- A greener RP-HPLC method for quaternary estimation of caffeine, paracetamol, levocetirizine, and phenylephrine acquiring AQbD with stability studies
- Optimization of biomass durian peel as a heterogeneous catalyst in biodiesel production using microwave irradiation
- Thermal treatment impact on the evolution of active phases in layered double hydroxide-based ZnCr photocatalysts: Photodegradation and antibacterial performance
- Preparation of silymarin-loaded zein polysaccharide core–shell nanostructures and evaluation of their biological potentials
- Preparation and characterization of composite-modified PA6 fiber for spectral heating and heat storage applications
- Preparation and electrocatalytic oxygen evolution of bimetallic phosphates (NiFe)2P/NF
- Rod-shaped Mo(vi) trichalcogenide–Mo(vi) oxide decorated on poly(1-H pyrrole) as a promising nanocomposite photoelectrode for green hydrogen generation from sewage water with high efficiency
- Green synthesis and studies on citrus medica leaf extract-mediated Au–ZnO nanocomposites: A sustainable approach for efficient photocatalytic degradation of rhodamine B dye in aqueous media
- Cellulosic materials for the removal of ciprofloxacin from aqueous environments
- The analytical assessment of metal contamination in industrial soils of Saudi Arabia using the inductively coupled plasma technology
- The effect of modified oily sludge on the slurry ability and combustion performance of coal water slurry
- Eggshell waste transformation to calcium chloride anhydride as food-grade additive and eggshell membranes as enzyme immobilization carrier
- Synthesis of EPAN and applications in the encapsulation of potassium humate
- Biosynthesis and characterization of silver nanoparticles from Cedrela toona leaf extracts: An exploration into their antibacterial, anticancer, and antioxidant potential
- Enhancing mechanical and rheological properties of HDPE films through annealing for eco-friendly agricultural applications
- Immobilisation of catalase purified from mushroom (Hydnum repandum) onto glutaraldehyde-activated chitosan and characterisation: Its application for the removal of hydrogen peroxide from artificial wastewater
- Sodium titanium oxide/zinc oxide (STO/ZnO) photocomposites for efficient dye degradation applications
- Effect of ex situ, eco-friendly ZnONPs incorporating green synthesised Moringa oleifera leaf extract in enhancing biochemical and molecular aspects of Vicia faba L. under salt stress
- Biosynthesis and characterization of selenium and silver nanoparticles using Trichoderma viride filtrate and their impact on Culex pipiens
- Photocatalytic degradation of organic dyes and biological potentials of biogenic zinc oxide nanoparticles synthesized using the polar extract of Cyperus scariosus R.Br. (Cyperaceae)
- Assessment of antiproliferative activity of green-synthesized nickel oxide nanoparticles against glioblastoma cells using Terminalia chebula
- Chlorine-free synthesis of phosphinic derivatives by change in the P-function
- Anticancer, antioxidant, and antimicrobial activities of nanoemulsions based on water-in-olive oil and loaded on biogenic silver nanoparticles
- Study and mechanism of formation of phosphorus production waste in Kazakhstan
- Synthesis and stabilization of anatase form of biomimetic TiO2 nanoparticles for enhancing anti-tumor potential
- Microwave-supported one-pot reaction for the synthesis of 5-alkyl/arylidene-2-(morpholin/thiomorpholin-4-yl)-1,3-thiazol-4(5H)-one derivatives over MgO solid base
- Screening the phytochemicals in Perilla leaves and phytosynthesis of bioactive silver nanoparticles for potential antioxidant and wound-healing application
- Graphene oxide/chitosan/manganese/folic acid-brucine functionalized nanocomposites show anticancer activity against liver cancer cells
- Nature of serpentinite interactions with low-concentration sulfuric acid solutions
- Multi-objective statistical optimisation utilising response surface methodology to predict engine performance using biofuels from waste plastic oil in CRDi engines
- Microwave-assisted extraction of acetosolv lignin from sugarcane bagasse and electrospinning of lignin/PEO nanofibres for carbon fibre production
- Biosynthesis, characterization, and investigation of cytotoxic activities of selenium nanoparticles utilizing Limosilactobacillus fermentum
- Highly photocatalytic materials based on the decoration of poly(O-chloroaniline) with molybdenum trichalcogenide oxide for green hydrogen generation from Red Sea water
- Highly efficient oil–water separation using superhydrophobic cellulose aerogels derived from corn straw
- Beta-cyclodextrin–Phyllanthus emblica emulsion for zinc oxide nanoparticles: Characteristics and photocatalysis
- Assessment of antimicrobial activity and methyl orange dye removal by Klebsiella pneumoniae-mediated silver nanoparticles
- Influential eradication of resistant Salmonella Typhimurium using bioactive nanocomposites from chitosan and radish seed-synthesized nanoselenium
- Antimicrobial activities and neuroprotective potential for Alzheimer’s disease of pure, Mn, Co, and Al-doped ZnO ultra-small nanoparticles
- Green synthesis of silver nanoparticles from Bauhinia variegata and their biological applications
- Synthesis and optimization of long-chain fatty acids via the oxidation of long-chain fatty alcohols
- Eminent Red Sea water hydrogen generation via a Pb(ii)-iodide/poly(1H-pyrrole) nanocomposite photocathode
- Green synthesis and effective genistein production by fungal β-glucosidase immobilized on Al2O3 nanocrystals synthesized in Cajanus cajan L. (Millsp.) leaf extracts
- Green stability-indicating RP-HPTLC technique for determining croconazole hydrochloride
- Green synthesis of La2O3–LaPO4 nanocomposites using Charybdis natator for DNA binding, cytotoxic, catalytic, and luminescence applications
- Eco-friendly drugs induce cellular changes in colistin-resistant bacteria
- Tangerine fruit peel extract mediated biogenic synthesized silver nanoparticles and their potential antimicrobial, antioxidant, and cytotoxic assessments
- Green synthesis on performance characteristics of a direct injection diesel engine using sandbox seed oil
- A highly sensitive β-AKBA-Ag-based fluorescent “turn off” chemosensor for rapid detection of abamectin in tomatoes
- Green synthesis and physical characterization of zinc oxide nanoparticles (ZnO NPs) derived from the methanol extract of Euphorbia dracunculoides Lam. (Euphorbiaceae) with enhanced biosafe applications
- Detection of morphine and data processing using surface plasmon resonance imaging sensor
- Effects of nanoparticles on the anaerobic digestion properties of sulfamethoxazole-containing chicken manure and analysis of bio-enzymes
- Bromic acid-thiourea synergistic leaching of sulfide gold ore
- Green chemistry approach to synthesize titanium dioxide nanoparticles using Fagonia Cretica extract, novel strategy for developing antimicrobial and antidiabetic therapies
- Green synthesis and effective utilization of biogenic Al2O3-nanocoupled fungal lipase in the resolution of active homochiral 2-octanol and its immobilization via aluminium oxide nanoparticles
- Eco-friendly RP-HPLC approach for simultaneously estimating the promising combination of pentoxifylline and simvastatin in therapeutic potential for breast cancer: Appraisal of greenness, whiteness, and Box–Behnken design
- Use of a humidity adsorbent derived from cockleshell waste in Thai fried fish crackers (Keropok)
- One-pot green synthesis, biological evaluation, and in silico study of pyrazole derivatives obtained from chalcones
- Bio-sorption of methylene blue and production of biofuel by brown alga Cystoseira sp. collected from Neom region, Kingdom of Saudi Arabia
- Synthesis of motexafin gadolinium: A promising radiosensitizer and imaging agent for cancer therapy
- The impact of varying sizes of silver nanoparticles on the induction of cellular damage in Klebsiella pneumoniae involving diverse mechanisms
- Microwave-assisted green synthesis, characterization, and in vitro antibacterial activity of NiO nanoparticles obtained from lemon peel extract
- Rhus microphylla-mediated biosynthesis of copper oxide nanoparticles for enhanced antibacterial and antibiofilm efficacy
- Harnessing trichalcogenide–molybdenum(vi) sulfide and molybdenum(vi) oxide within poly(1-amino-2-mercaptobenzene) frameworks as a photocathode for sustainable green hydrogen production from seawater without sacrificial agents
- Magnetically recyclable Fe3O4@SiO2 supported phosphonium ionic liquids for efficient and sustainable transformation of CO2 into oxazolidinones
- A comparative study of Fagonia arabica fabricated silver sulfide nanoparticles (Ag2S) and silver nanoparticles (AgNPs) with distinct antimicrobial, anticancer, and antioxidant properties
- Visible light photocatalytic degradation and biological activities of Aegle marmelos-mediated cerium oxide nanoparticles
- Physical intrinsic characteristics of spheroidal particles in coal gasification fine slag
- Exploring the effect of tea dust magnetic biochar on agricultural crops grown in polycyclic aromatic hydrocarbon contaminated soil
- Crosslinked chitosan-modified ultrafiltration membranes for efficient surface water treatment and enhanced anti-fouling performances
- Study on adsorption characteristics of biochars and their modified biochars for removal of organic dyes from aqueous solution
- Zein polymer nanocarrier for Ocimum basilicum var. purpurascens extract: Potential biomedical use
- Green synthesis, characterization, and in vitro and in vivo biological screening of iron oxide nanoparticles (Fe3O4) generated with hydroalcoholic extract of aerial parts of Euphorbia milii
- Novel microwave-based green approach for the synthesis of dual-loaded cyclodextrin nanosponges: Characterization, pharmacodynamics, and pharmacokinetics evaluation
- Bi2O3–BiOCl/poly-m-methyl aniline nanocomposite thin film for broad-spectrum light-sensing
- Green synthesis and characterization of CuO/ZnO nanocomposite using Musa acuminata leaf extract for cytotoxic studies on colorectal cancer cells (HCC2998)
- Review Articles
- Materials-based drug delivery approaches: Recent advances and future perspectives
- A review of thermal treatment for bamboo and its composites
- An overview of the role of nanoherbicides in tackling challenges of weed management in wheat: A novel approach
- An updated review on carbon nanomaterials: Types, synthesis, functionalization and applications, degradation and toxicity
- Special Issue: Emerging green nanomaterials for sustainable waste management and biomedical applications
- Green synthesis of silver nanoparticles using mature-pseudostem extracts of Alpinia nigra and their bioactivities
- Special Issue: New insights into nanopythotechnology: current trends and future prospects
- Green synthesis of FeO nanoparticles from coffee and its application for antibacterial, antifungal, and anti-oxidation activity
- Dye degradation activity of biogenically synthesized Cu/Fe/Ag trimetallic nanoparticles
- Special Issue: Composites and green composites
- Recent trends and advancements in the utilization of green composites and polymeric nanocarriers for enhancing food quality and sustainable processing
- Retraction
- Retraction of “Biosynthesis and characterization of silver nanoparticles from Cedrela toona leaf extracts: An exploration into their antibacterial, anticancer, and antioxidant potential”
- Retraction of “Photocatalytic degradation of organic dyes and biological potentials of biogenic zinc oxide nanoparticles synthesized using the polar extract of Cyperus scariosus R.Br. (Cyperaceae)”
- Retraction to “Green synthesis on performance characteristics of a direct injection diesel engine using sandbox seed oil”